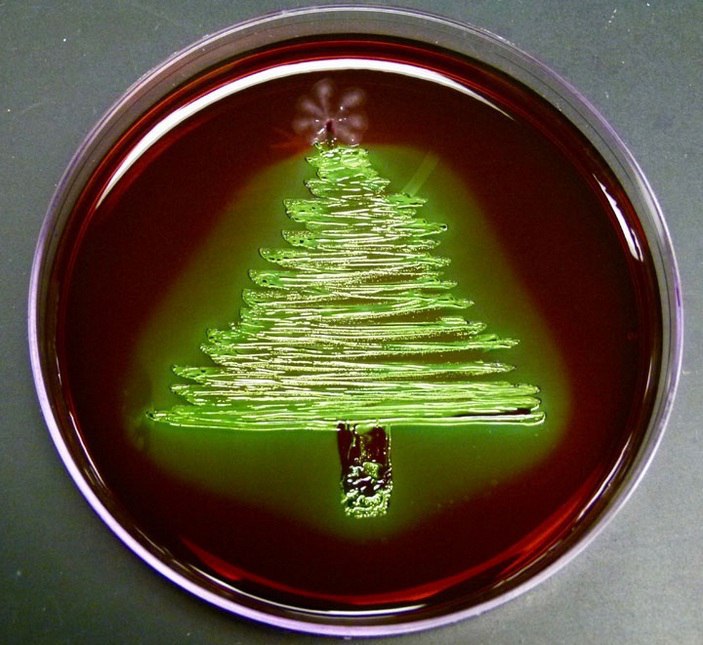

Сергей
Сергей
Zix
Zix

 Denis
Denis

 ᛞᛁᛉᛗᛟᚱᚨᛚ
ᛞᛁᛉᛗᛟᚱᚨᛚ
Вот они запилили новый редактор, тем, почему нельзя все по-нормальному сделать? Когда с классической на ночную вручную переключаешь, обратно на классическую переключаться не хочет
 ᛞᛁᛉᛗᛟᚱᚨᛚ
ᛞᛁᛉᛗᛟᚱᚨᛚ
Кнопка переключения отвечает, а тема не переключается
И когда классическую тему меняю, захожу в редактор и все тупо сбрасывется
 Нет Войне
Нет Войне
Помогите! Как отключить анимацию в интерфейсе Telegram? Всё еле ползает. Даже текст набирается медленнее, чем раньше.
 Сергей
Сергей
 Нет Войне
Нет Войне

 veewo
veewo
Вы знали что можно копировать предложение сразу из отправленного сообщения?
да, в этой обнове добавили)
 Нет Войне
Нет Войне
Вы знали что можно копировать предложение сразу из отправленного сообщения?
Это как поздравлять раненого с тем, что пуля была произведена по новой, десятинанометровой технологии. Спасибо.
 Antonio
Antonio
Вы знали что можно копировать предложение сразу из отправленного сообщения?
а вы думали подсказку только вам показали?)
 Antonio
Antonio
Это как поздравлять раненого с тем, что пуля была произведена по новой, десятинанометровой технологии. Спасибо.
а кто сказал что кто-то вас поздравляет?
 Antonio
Antonio
Ну камон, зачем столько токсичности, ребята
тоже не понимаю, но человек обиделся наверное, на то, что телега тупит
 Нет Войне
Нет Войне
кажется там просто очень старый девайс, поэтому и тупит
Для всех приложений не старый, для Телеграма старый. Samsung S5.
 Groosha
Groosha
Для всех приложений не старый, для Телеграма старый. Samsung S5.
Попробуй Telegram X, мож пошустрее будет
 Нет Войне
Нет Войне
тоже не понимаю, но человек обиделся наверное, на то, что телега тупит
Потому что это очень важное для меня приложение.
 Нет Войне
Нет Войне
Попробуй Telegram X, мож пошустрее будет
Спасибо за совет. Наверное, придётся. Никогда им не пользовался
 ᛞᛁᛉᛗᛟᚱᚨᛚ
ᛞᛁᛉᛗᛟᚱᚨᛚ
Ну че, давайте темами делиться
https://t.me/addtheme/RaM361mWXfYss7bU
https://t.me/addtheme/a78iki2Kk6HEdRlw
 Нет Войне
Нет Войне
Попробуй Telegram X, мож пошустрее будет
Это спасение, хотя тормознее оригинального Телеграма. При выборе канала срабатывает анимация в виде распространяющейся от центра подсветки, это тоже тормоза, хотя и не слайдшоу, вот зачем. А ещё позиционируют себя как "
 Vitaly
Vitaly
 Нет Войне
Нет Войне
An alternative Telegram client with higher speed" — ну не стыдно врать?
Хотя с сегодняшнего дня это правда, higher speed.
 Нет Войне
Нет Войне
Помогло?
Нет. Но я уже к мелочам придираюсь. В принципе, это уровень скорости прошлой версии Телеграма, то есть сам переход на X помог.
 Antonio
Antonio
Для всех приложений не старый, для Телеграма старый. Samsung S5.
Я конечно ничего не хочу сказать, но смартфон которому больше 5 лет является старым :(
 Нет Войне
Нет Войне
Я конечно ничего не хочу сказать, но смартфон которому больше 5 лет является старым :(
Вы именно это хотите сказать. Но есть старые добротные вещи. Некоторые новые смартфоны хуже и тормознее, чем мой "старик"
 Antonio
Antonio
Вы именно это хотите сказать. Но есть старые добротные вещи. Некоторые новые смартфоны хуже и тормознее, чем мой "старик"
Зачем вы за меня какие-то аргументы придумываете?
Я сказал что девайс старый и я имел в виду что он старый, так и есть, и спорить готов что сейчас новые устройства не могут больше тормозить чем смартфон которому 5 лет
P.S. И Telegram X через какое-то время начнёт тормозить на вашем "добротном" устройстве


 Ivan
Ivan
 Sehio
Sehio






 Bolodya🔥
Bolodya🔥

 Dmitry
Dmitry


